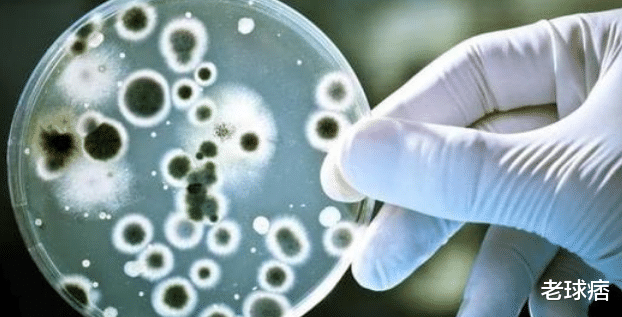
【科学家】为了永生，一个注射340万年前的细菌，一个注射乌龟血液，最后谁成功了？

【科学家】为了永生,一个注射340万年前的细菌,一个注射乌龟血液,最后谁成功了?
文章图片

文章图片
永生是人类一直都在追求的事情 , 前有秦始皇派徐福去蓬莱求药 , 后有疯狂科学家慰劳永生注射340万年前的细菌 。 甚至还有人去注射乌龟血液 , 那么他们最后都成功了吗?永生究竟是可行还是不可行呢?
其实人不想死这谁都能理解 , 但是我们不能为了永生就做出一些不合时宜的事情 。 之前有一个科研团队发现了西伯利亚冻土层下存活了340万年前的细菌 , 他们将这个细菌带回去研究 。 其中有一个科学家发现这种细菌生命里很顽强 , 所以他就将这个细菌先注射到小白鼠身上 , 意外发现这个小白鼠生命竟然真的延长了 , 而且比之前更加强 。
所以科学家就将细菌也注射在自己体内 , 前两年他没有任何不适症状 , 而且从来没有生病 。 他狂喜不已 , 还真的以为自己发现了可以永生的细菌 , 结果2年之后 , 他身体开始快速衰老 。 其实永生真的不能实现 , 何必去强行苛求呢?这个科学家不是个例 , 后来还有人觉得乌龟寿命那么长 , 如果注射乌龟血液可以达到永生吧?
所以这个人注射了乌龟血液 , 结果大家也能猜到 , 这个人自然没有达到永生目的 。 要知道乌龟之所以可以永生 , 不仅仅是因为它们血液 , 还跟它们活动居住环境有关 。 我们一生的确很短暂 , 那么我们利用好这短暂一生去做其他有意义的事情不是更好吗?那么你们认为将来人类可以达到永生吗?【【科学家】为了永生,一个注射340万年前的细菌,一个注射乌龟血液,最后谁成功了?】
推荐阅读
- 科学家■如果宇宙由奇点大爆炸而来,那么奇点又是如何来的?
- 『南极』科学家在南极冰下800米处,发现新的生命世界,颠覆了人类的认知
- 【科学家】科学家公布首张宇宙全景高清图像,在宇宙之外又是什么呢?
- 科学家▲科学家发现宇宙的终极是熵,这意味着什么?未来世界将一片混乱!
- 严胖子黑科技|有水有大气!,人类移居有望了?科学家:两颗“超级地球”被发现
- #冠状病毒#科学家警告说:冠状病毒已经变异成一种新的、更具传染性的毒株
- 天文在线|宇宙会以什么样的方式结束?科学家给出了不同的预测
- 黑洞使者|科学家:或可用大气矿尘寻找外星生命,“第二地球”判定标准来了
- 『太阳系』太阳系的上方和下方到底是什么?科学家的发现,让人类深思!
- :“异形”上演?被吞下后又破膛而出,为了活下去你想不到多恐怖!
